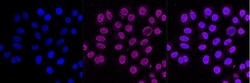
Invitrogen Nicastrin Recombinant Rabbit Monoclonal Antibody (23GB1040),

missing translation for 'onlineSavingsMsg'
Learn More
Learn More
Invitrogen™ Nicastrin Recombinant Rabbit Monoclonal Antibody (23GB1040), Invitrogen™
Rabbit Recombinant Monoclonal Antibody
Brand: Invitrogen™ MA553745
This item is not returnable.
View return policy
Description
NCSTN (Nicastrin) is a gene that encodes a type I transmembrane glycoprotein that is an integral component of the multimeric gamma-secretase complex. The encoded protein cleaves integral membrane proteins, including Notch receptors and beta-amyloid precursor protein, and may be a stabilizing cofactor required for gamma-secretase complex assembly. The cleavage of beta-amyloid precursor protein yields amyloid beta peptide, the main component of the neuritic plaque and the hallmark lesion in the brains of patients with Alzheimer's disease; however, the nature of the encoded protein's role in Alzheimer's disease is not known for certain. Mutations in this gene are associated with familial acne inversa. A pseudogene of this gene is present on chromosome 21.
Specifications
| Nicastrin | |
| Recombinant Monoclonal | |
| Unconjugated | |
| NCSTN | |
| 9430068N19Rik; AA727311; anterior pharynx-defective 2; Aph2; ATAG1874; D1Dau13e; Kiaa0253; mKIAA0253; NCSTN; Nct; Nicastrin; OTTHUMP00000031840; UNQ1874/PRO4317 | |
| Rabbit | |
| Affinity chromatography | |
| RUO | |
| 23385, 289231, 59287 | |
| -20°C | |
| Liquid |
| Flow Cytometry, Western Blot, Immunocytochemistry | |
| 23GB1040 | |
| PBS with 50% glycerol and 0.02% sodium azide; pH 7.4 | |
| P57716, Q8CGU6, Q92542 | |
| NCSTN | |
| A synthetic peptide of human Nicastrin (696-709AA). | |
| 20 μL | |
| Primary | |
| Human, Mouse, Rat | |
| Antibody | |
| IgG |
Product Content Correction
Your input is important to us. Please complete this form to provide feedback related to the content on this product.
Product Title
Spot an opportunity for improvement?Share a Content Correction